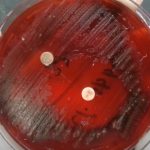
Anaerobes Presumptive Identification using Antibiotic disks: Introduction, Principle, Procedure, Result Interpretation and Keynotes

Tag: Principle of Anaerobes Presumptive Identification using Antibiotic disks
Anaerobes Presumptive Identification using Antibiotic disks: Introduction, Principle, Procedure, Result Interpretation and Keynotes
Introduction of Anaerobes Presumptive Identification using Antibiotic disks Anaerobes Presumptive Identification...
Introduction of Anaerobes Presumptive Identification using Antibiotic disks Anaerobes Presumptive Identification...
